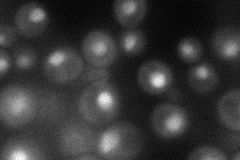
YML015C
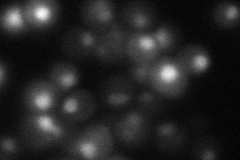
YML015C
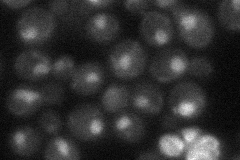
YML015C
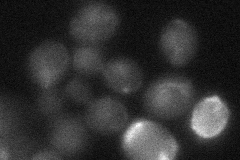
YML015C
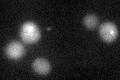
YML015C

View description
TFIID subunit (40 kDa), involved in RNA polymerase II transcription initiation, similar to histone H3 with atypical histone fold motif of Spt3-like transcription factors
Localization:
Intensity:
Fold change:
Significance:
-
C’ GFP library in SD

below threshold16.47 -
N' NOP1pr-GFP in SD
cytosol,nucleus40.83 -
N' TEF2pr-mCherry in SD
cytosol,nucleus52.8151 -
N' NATIVEpr-GFP in SD
nucleus29.6903 -
N' TEF2pr-VC and Cyto-VN in SD
below threshold25.8559 -
C’ GFP library in SD+DTT
cytosol16.941.02No -
C’ GFP library in SD+H2O2

cytosol17.791.08No -
C’ GFP library in Starvation Media

cytosol16.921.02No -
C’ GFP library on the background of Pup2-DaMP

below threshold -
C’ GFP library on the background of CCT mutant

below threshold18.0831.09782No
